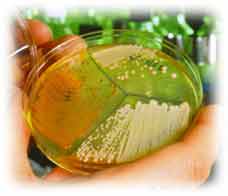
Culture bact�rienne..

Photographie : Conseil national de recherches du Canada
Les bactéries sont des procaryotes, ce qui signifie qu'elles ne contiennent pas de noyau. Bien qu'ils prolifèrent souvent en groupes où les bactéries adhèrent l'une à l'autre, les procaryotes sont composés d'une seule cellule. On appelle ces groupes de bactéries des colonies. Le génome bactérien comprend un grande molécule circulaire d'ADN bicaténaire située dans le cytoplasme cellulaire. Cette grande molécule d'ADN, le chromosome bactérien, contient la plupart des gènes bactériens. Outre cette grande molécule d'ADN, les bactéries renferment souvent de petites molécules d'ADN circulaires appelées plasmides. Ces plasmides contiennent également des gènes, mais contrairement au grand chromosome circulaire, ils sont extrêmement mobiles. Ils peuvent passer facilement d'une bactérie à l'autre, et, de cette façon, les gènes sont transmis entre bactéries. Les molécules de plasmide, une fois dans la cellule bactérienne hôte, peuvent s'intégrer en permanence au grand chromosome bactérien.

La capacité des plasmides à pénétrer dans les cellules bactériennes et à s'intégrer au chromosome de ces cellules en fait des outils très utiles pour insérer un gène dans une cellule bactérienne. Pouvez-vous voir comment? Nous vous expliquerons comment les plasmides sont employés de cette façon dans la section portant sur le génie génétique.


